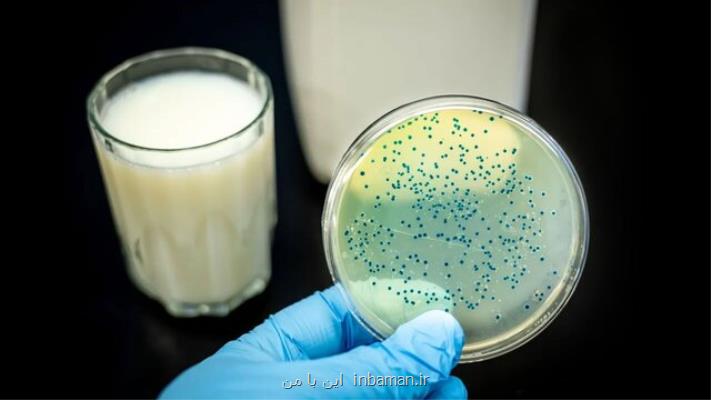

محققان كشور ارائه كردند
پلاسمای سرد، روشی نوین برای رفع آلودگی شیر
این با من: رفع آلودگی های احتمالی از مواد غذایی، همیشه یکی از اهداف مهم پژوهشگران برای انجام تحقیق و پژوهش بوده است. در یکی از همین تلاش ها، پژوهشگران کشور استفاده از روشی نوین به نام سیستم پلاسمای سرد را برای میکروب کشی لبنیات و بطور ویژه شیر با موفقیت آزموده اند.
این با من: رفع آلودگی های احتمالی از مواد غذایی، همیشه یکی از اهداف مهم پژوهشگران برای انجام تحقیق و پژوهش بوده است. در یکی از همین تلاش ها، پژوهشگران کشور استفاده از روشی نوین به نام سیستم پلاسمای سرد را برای میکروب کشی لبنیات و بطور ویژه شیر با موفقیت آزموده اند.
به گزارش این با من به نقل از ایسنا، نابودی میکروارگانیسم ها در مواد غذایی، یکی از بزرگ ترین چالش های صنایع فرآوری مواد غذایی است. متأسفانه روش های سنتی پاستوریزاسیون و استریلیزاسیون به شکل بارزی بر کیفیت شیر اثر گذاشته و منجر به قهوه ای شدن آنزیمی، ازدست رفتن ویتامین ها و طعم و تغییرات ساختاری پروتئین ها می شوند. شیر گاو در کل جهان مصرف می شود. ترکیبات موجود در شیر گاو شامل ۸۷۰ گرم در لیتر آب، ۴۹۰ گرم در لیتر قند لاکتوز، ۳۴۰ گرم در لیتر چربی، ۳۳ گرم در لیتر پروتئین و ۷ گرم در لیتر ویتامین و مواد معدنی هستند. ایمنی شیر و درنتیجه افزایش زمان ماندگاری آن، اغلب توسط فرآوری حرارتی شامل پاستوریزاسیون یا استریلیزاسیون و همین طور فرایندهایی نظیر تخمیر و رساندن مانند تولید پنیر ایجاد می شود.
بنا بر گفته های متخصصان، امروزه باوجود ورود تکنولوژی های نوین مانند فشار بالا، مایکروویو، میدان های الکتریکی پالسی و نظایر این ها، هنوز هم برای نابودی میکروارگانیسم ها اغلب نیاز به استفاده از حرارت وجود دارد. در بعضی موارد بمنظور نابودی میکروارگانیسم های هدف، استفاده از اینگونه حرارت های بالا مانند آنچه در پروسه استریلیزاسیون اعمال می شود، موجب نابودی ترکیبات تغذیه ای در مقیاس وسیع می گردد. علاوه بر آن، تغییر طعم، بو، بافت، رنگ و خاصیت های ظاهری نیز از نتایج منفی استفاده از حرارت برای سالم سازی شیر و سایر مواد غذایی است. بنا بر این محققین این حوزه همیشه بدنبال راهکارهای جایگزین یا تلفیقی از روش ها برای کاهش استفاده از حرارت های بالا بوده اند.
در همین رابطه، یکی از پژوهشگران کشور از دانشگاه علوم کشاورزی و منابع طبیعی ساری در یک مطالعه مروری، کاربرد پلاسمای سرد برای بهینه سازی نابودی پاتوژن های شاخص و بررسی تغییرات کیفی شیر بطری شده مورد بررسی قرار داده است.
در این مطالعه، سیستمی موسوم به «پلاسمای تخلیه سطح» شامل یک سیستم استوانه ای و الکترود برای اعمال روی شیر درون بطری استفاده شد. سپس زمان نابودی میکروارگانیسم های باسیلوس سرئوس، باسیلوس کواگالانز، باسیلوس استئاروترموفیلوس و کلستریدیوم بوتولینوم بررسی گردید. همین طور وضعیت ترکیبات تغذیه ای و بروز واکنش های شیمیایی و میزان زمان غیرفعال سازی آنزیم های مختلف شیر مورد ارزیابی قرار گرفت.
نتایج این تحقیق نشان دادند فناوری پلاسمای سرد می تواند به عنوان یک مداخله ضدمیکروبی جدید برای غیرفعال کردن پاتوژن ها و بهبود ایمنی محصولات لبنی مورد استفاده قرار گیرد.
آن گونه که آزاده رنجبر ندامانی، محقق گروه مکانیک بیوسیستم دانشگاه علوم کشاورزی و منابع طبیعی ساری می گوید، «باکتری باسیلوس استئاروترموفیلوس بیشترین مقاومت در مقابل اعمال پلاسمای سرد را داشته و پس از آن سایر باکتری ها مقاومت نزدیکی از خود نشان داده اند. تغییرات دمای اولیه نسبت به تغییرات ولتاژ، اثر بیشتری بر میزان تولید رادیکال های آزاد داشت».
این محقق می افزاید: «فناوری پلاسمای سرد می تواند به عنوان یک روش ضدمیکروبی جدید برای غیرفعال کردن پاتوژن ها و بهبود ایمنی محصولات لبنی مورد استفاده قرار گیرد. این تکنیک که به عنوان ایمن برای محیط زیست نیز طبقه بندی می شود، با تمام استانداردهای زیست محیطی مطابقت دارد و دارای راندمان غیرفعال سازی میکروبی بالا در دماهای پایین و تأثیر کم بر وضعیت تغذیه ای محصول است».
بر اساس پیشنهاد این پژوهشگر، در آینده لازم است بررسی های بیشتری برای روشن کردن اثرات پلاسمای سرد بر پارامترهای کیفی محصولات لبنی، همچون خاصیت های حسی، حفظ ارزش غذایی و پایداری در طول نگهداری آنها صورت گیرد.
رنجبر ندامانی همین طور با انتشار نتایج مطالعه خود در نشریه «پژوهش و نوآوری در علوم و صنایع غذایی» به این نکته اشاره نموده است که اثر فناوری پلاسمای غیرحرارتی را می توان در پژوهش های دیگر با انواع عملیات حرارتی مرسوم نظیر پاستوریزه و استریلیزه کردن به شکل علمی مقایسه نمود.
قابل ذکر است، نشریه یاد شده فوق توسط مؤسسه پژوهشی علوم و صنایع غذایی و در قالب فصل نامه منتشر می گردد.
منبع: inbaman.ir
این مطلب را می پسندید؟
(1)
(0)
تازه ترین مطالب مرتبط
نظرات بینندگان در مورد این مطلب
نظر شما در مورد این مطلب
نام:
ایمیل:
نظر:
سوال:
= ۹ بعلاوه ۳